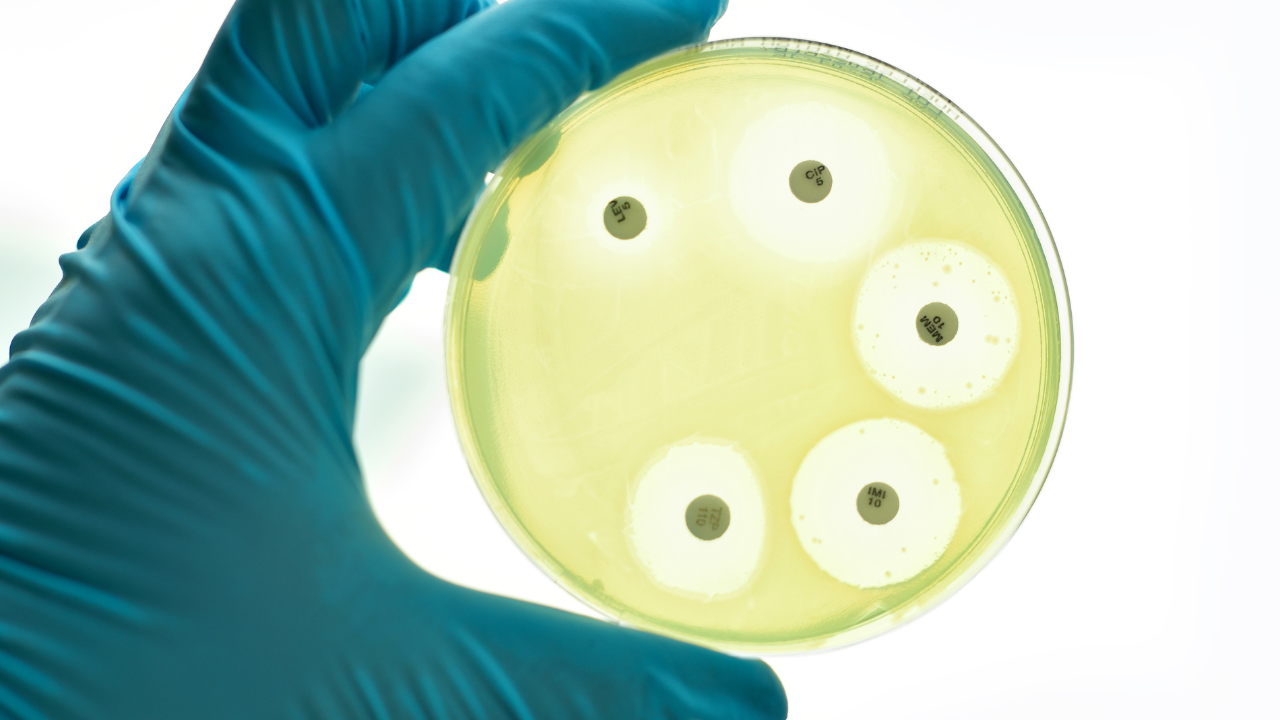
Résistance aux antimicrobiens (RAM) et qualité au laboratoire

La RAM: une menace croissante qui interpelle directement les laboratoires
La résistance aux antimicrobiens (RAM) est aujourd’hui reconnue comme l’une des plus grandes menaces pour la santé publique mondiale. En Afrique, son impact est encore plus critique : infections courantes qui ne répondent plus aux traitements, durée d’hospitalisation prolongée, coûts élevés pour les patients, et augmentation de la mortalité.
Dans ce contexte, les laboratoires jouent un rôle central, car c’est à travers eux que la RAM est surveillée, détectée et mesurée.
Mais pour que ces informations soient fiables, utiles et exploitables par les cliniciens et les programmes nationaux, la gestion de la qualité devient un élément non négociable. Sans système qualité solide, les laboratoires ne peuvent ni garantir l’exactitude des antibiogrammes, ni assurer la détection correcte des mécanismes de résistance, ni fournir des données fiables pour la surveillance nationale.
Dans de nombreux pays africains, les laboratoires font face à des contraintes réelles : ressources limitées, manque de formation continue, rupture de réactifs, faible culture qualité, ou encore équipements non entretenus. Pourtant, ces défis ne diminuent pas leur importance dans la lutte contre la RAM. Au contraire : ils renforcent l’urgence d’un système de gestion de la qualité (SGQ) adapté, simple, réaliste et appliqué au quotidien.
La lutte contre la RAM n’est pas uniquement une question de molécules et d’antibiotiques. C’est aussi — et surtout — une question de fiabilité des résultats. Et cela commence par un laboratoire organisé, standardisé, conforme aux exigences qualité, capable de produire des antibiogrammes justes et reproductibles.
🎧 Pour aller au-delà de la théorie, j’ai souhaité recueillir la voix d’un acteur clé de la lutte contre la RAM au Cameroun.
J’ai donc échangé avec le Dr Sandrine TONMEU, du Laboratoire National de Santé Publique (LNSP), qui accompagne au quotidien les laboratoires dans la surveillance et la détection des résistances.
Dans cet extrait audio, elle revient sur le lien entre RAM et qualité des analyses, le dispositif national d'accompagnement en qualité et les perspectives.
👉 Prenez un instant pour écouter cet audio avant de poursuivre l’article : il apporte un regard concret et essentiel
Le rôle essentiel des laboratoires dans la lutte contre la RAM
Face à la montée inquiétante de la résistance aux antimicrobiens, les laboratoires sont au cœur de la réponse. Sans résultats fiables, il est impossible de surveiller l’évolution des résistances, d’orienter les traitements, ou de guider les politiques nationales.
Le premier rôle du laboratoire est d’identifier l’agent pathogène responsable d’une infection. Une mauvaise identification conduit à des traitements inadaptés, favorisant la sélection de résistances.
Les antibiogrammes représentent la base de toute décision thérapeutique rationnelle. Ils permettent de savoir si le microorganisme est sensible, intermédiaire ou résistant à un antibiotique.
Sans antibiogrammes fiables, les cliniciens prescrivent “à l’aveugle”.
Certains mécanismes nécessitent une expertise spécifique.
Le laboratoire joue un rôle clé dans leur détection précoce, indispensable pour limiter la propagation dans les hôpitaux et la communauté.
Les programmes nationaux de surveillance de la RAM reposent à 100 % sur les laboratoires.
Chaque antibiogramme contribue à une base de données permettant d’identifier les tendances de résistance, les éclosions hospitalières, les zones critiques à cibler.
Le laboratoire n’est pas seulement un “producteur de résultats”.
Il joue un rôle consultatif essentiel : interprétations, recommandations thérapeutiques, alertes sur les résistances inhabituelles. Il soutient ainsi la prescription judicieuse des antibiotiques
Les données fournies par le laboratoire permettent d’orienter les actions d’hygiène, de détecter des infections nosocomiales et d’aider à la maîtrise des foyers de résistance.
Les enjeux et problèmes actuels dans la lutte contre la RAM au niveau des laboratoires
Bien que les laboratoires représentent la base scientifique de la lutte contre la résistance aux antimicrobiens, ils se heurtent à plusieurs défis majeurs qui compromettent la fiabilité des données et l’efficacité des interventions de santé publique. Ces enjeux sont particulièrement visibles dans les contextes à faibles ressources.
Dans de nombreux laboratoires, les antibiogrammes sont réalisés sans procédures harmonisées, avec des disques périmés, des milieux de culture inadaptés ou des contrôles qualité insuffisants.
Résultat : des profils de résistance erronés, conduisant à des traitements inadaptés et à une mauvaise compréhension de la réalité nationale.
Les guides de référence existent, mais ne sont pas toujours maîtrisés ou appliqués.
Cette absence d’alignement crée une variabilité importante des résultats d’un laboratoire à l’autre, rendant difficile la comparaison des données et la consolidation nationale.
Les délais de livraison, les budgets limités et l’absence de planification qualité entraînent :
• des interruptions de tests,
• des choix de réactifs “par défaut”,
• ou l’utilisation de kits de qualité incertaine. Ces contraintes logistiques ont un impact direct sur la capacité des laboratoires à détecter les résistances.
Le CQI (contrôle qualité interne) est encore considéré comme “optionnel” dans certains contextes, alors qu’il est indispensable pour garantir l’exactitude des résultats.
Le faible accès aux programmes d’EEQ (évaluation externe de la qualité) prive les laboratoires d’un regard objectif sur leurs performances.
La résistance aux antimicrobiens nécessite des compétences techniques pointues :
• lecture standardisée des antibiogrammes,
• interprétation selon les normes,
• détection des mécanismes de résistance. À cela s’ajoute une faible culture qualité, rendant difficile la mise en œuvre d’un système qualité complet.
Dans plusieurs pays, les laboratoires périphériques ou privés n’envoient pas systématiquement leurs données au niveau central de coordination.
Cela limite la visibilité réelle du phénomène RAM et rend difficile la prise de décisions informées.
Beaucoup de laboratoires fonctionnent sans procédures écrites, sans enregistrement rigoureux et sans traçabilité.
Or sans documentation, il n’y a pas de qualité, ni de preuve de conformité.
Comment le système qualité renforce la lutte contre la résistance aux antimicrobiens
La gestion de la qualité n’est pas une “option administrative”.
C’est une stratégie opérationnelle incontournable pour produire des résultats fiables, comparables et exploitables.
Voici comment l'assurance qualité transforme concrètement la contribution du laboratoire contre la RAM.
1. Standardisation des méthodes = résultats fiables et comparables
Un système qualité impose des procédures écrites et harmonisées, permettant de réduire la variabilité des antibiogrammes et augmente leur fiabilité.
2. Contrôles qualité réguliers = détection précoce des dérives
Le CQI permet d’identifier rapidement les erreurs internes. L’EEQ (évaluation externe de la qualité) complète ce dispositif et prouve que le laboratoire maîtrise ses performances.
3. Documentation rigoureuse = traçabilité et preuve de conformité
Les enregistrements permettent de prouver que les conditions de test sont maîtrisées. Sans documentation, aucune structure nationale ne peut s’appuyer sur les données du labo.
4. Formation continue = compétences techniques renforcées
Une culture qualité implique des formations régulières :
• bonnes pratiques de microbiologie,
• lecture standardisée des antibiogrammes,
• interprétation avancée de la résistance.
Ceci est indispensable pour limiter les erreurs humaines, encore fréquentes dans les contextes à faible ressources.
5. Maintenance et gestion des équipements = résultats reproductibles
La calibration, la vérification et l’entretien des équipements (incubateurs, réfrigérateurs, microscopes) garantissent la stabilité des conditions expérimentales.
Sans maintenance : les résultats deviennent aléatoires.
6. Gestion des réactifs et achats planifiés = réductions des ruptures
Un bon système d'approvisionnement évite les ruptures qui interrompent les antibiogrammes ou obligent à utiliser des alternatives non validées.
7. Amélioration continue = détection et correction des non-conformités
Le système qualité encourage la déclaration des erreurs et des incidents, non pour sanctionner, mais pour apprendre et améliorer. Cette dynamique renforce la fiabilité des données sur la RAM.
Pour finir
La résistance aux antimicrobiens n’est pas un défi lointain. Elle touche nos hôpitaux, nos communautés, nos patients et nos systèmes de santé. Et au centre de cette bataille, il y a le laboratoire : un acteur discret mais indispensable.
Sans un système de gestion de la qualité solide, les antibiogrammes perdent leur valeur, les mécanismes de résistance passent inaperçus, les données nationales deviennent imprécises et la prise en charge des patients se dégrade.
À l’inverse, lorsqu’un laboratoire adopte des pratiques standardisées, documentées, contrôlées et améliorées en continu, il devient un pilier fiable de la lutte contre la RAM.
La qualité n’est donc pas un luxe. Et chaque professionnel de laboratoire — technicien, biologiste, responsable qualité — a un rôle essentiel à jouer.
Parce que la RAM ne s’arrêtera pas d’elle-même.
Mais un laboratoire organisé, compétent et engagé peut faire une différence concrète, chaque jour, résultat après résultat
Envie d’aller plus loin ?
Téléchargez ma fiche mémoire gratuite pour comprendre, en un coup d’œil, les mots clés du SGQ en laboratoire.
C’est un excellent premier pas pour renforcer la qualité dans vos pratiques quotidiennes